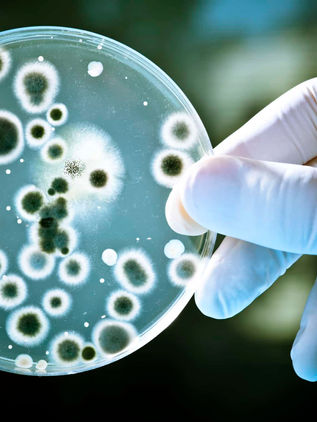
Desarrollan bacterias que comen CO2

top of page

Buscar


Congreso de Chiapas respalda proyectos de transformación ambiental tras visita presidencial
PALENQUE.- Con la presencia de la presidenta de México, Claudia Sheinbaum, y el gobernador Eduardo Ramírez, se llevó a cabo la inauguración del Ecoparque “La Ceiba”, un proyecto estratégico enfocado en la conservación ambiental y el turismo en Chiapas. Al evento asistió la presidenta del Congreso del Estado, Alejandra Gómez Mendoza, quien destacó la relevancia de estos espacios para fortalecer el tejido social y la convivencia familiar en la entidad. Durante el encuentro, Góm


Congreso de Chiapas respalda proyectos de transformación ambiental tras visita presidencial
PALENQUE.- Con la presencia de la presidenta de México, Claudia Sheinbaum, y el gobernador Eduardo Ramírez, se llevó a cabo la inauguración del Ecoparque “La Ceiba”, un proyecto estratégico enfocado en la conservación ambiental y el turismo en Chiapas. Al evento asistió la presidenta del Congreso del Estado, Alejandra Gómez Mendoza, quien destacó la relevancia de estos espacios para fortalecer el tejido social y la convivencia familiar en la entidad. Durante el encuentro, Góm


Alerta en Quechula: El templo hundido enfrenta un riesgo de colapso inminente
TECPATÁN, (Noé Juan Farrera).- El histórico templo de Santiago Apóstol en Quechula, una joya arquitectónica del siglo XVI, se encuentra bajo una amenaza de colapso inminente. La estructura, que emerge anualmente de las aguas de la presa Malpaso durante la temporada de estiaje, presenta un deterioro acelerado debido a décadas de inmersión y a la falta de regulación en el flujo de visitantes que acuden a admirar las ruinas. A pesar de su imponente fachada colonial, el contacto


Valeria Rosales y Margarita Sarmiento fortalecen la nutrición escolar en Villaflores
Villaflores.- La alcaldesa de Villaflores, Valeria Rosales Sarmiento, y la presidenta del DIF Municipal, Margarita Sarmiento Tovilla, encabezaron la entrega masiva de insumos para el programa de desayunos escolares. Durante el evento, se distribuyeron los recursos correspondientes al bimestre marzo-abril, con el objetivo de asegurar que los estudiantes del municipio mantengan una dieta sana y equilibrada que favorezca su rendimiento académico. En su intervención, la president


Aprobación presidencial registra su punto más bajo en lo que va del sexenio
CIUDAD DE MÉXICO, (EFE) .- La aprobación de la presidenta Claudia Sheinbaum registró su nivel más bajo en lo que va de su sexenio, situándose en un 68% durante el mes de abril. Según la encuesta más reciente del diario El Financiero, la mandataria ha experimentado un descenso constante desde febrero de 2025, cuando alcanzó un pico histórico del 85%, reflejando un desgaste en la percepción ciudadana tras siete meses de administración. El estudio revela que la economía y la seg


Aprobación presidencial registra su punto más bajo en lo que va del sexenio
CIUDAD DE MÉXICO, (EFE) .- La aprobación de la presidenta Claudia Sheinbaum registró su nivel más bajo en lo que va de su sexenio, situándose en un 68% durante el mes de abril. Según la encuesta más reciente del diario El Financiero, la mandataria ha experimentado un descenso constante desde febrero de 2025, cuando alcanzó un pico histórico del 85%, reflejando un desgaste en la percepción ciudadana tras siete meses de administración. El estudio revela que la economía y la seg


Economía Silver en México: El mercado de mayores de 50 años detonará el crecimiento regional
CIUDAD DE MÉXICO, (EFE).- El envejecimiento poblacional en México está abriendo la puerta a la denominada economía silver, un mercado que ya representa al 23% de los habitantes del país. Según datos presentados en el Silver Economy Congress 2026, se proyecta que para el año 2050 este sector alcance el 36% de la población nacional, posicionándose como un motor de crecimiento estratégico para las empresas y el sector financiero en América Latina. Expertos internacionales señala


Histórica reforma: México inicia transición a la jornada laboral de 40 horas
CDMX, (EFE).- México conmemora este Día Internacional del Trabajo con un hito histórico: la entrada en vigor de la reforma para reducir la jornada laboral de 48 a 40 horas. Aunque la implementación será progresiva y alcanzará su totalidad hasta el año 2030, la medida ha generado opiniones encontradas entre activistas, legisladores y el sector privado, quienes debaten sobre la claridad de los dos días de descanso obligatorios. Activistas y abogadas laboralistas advierten que l


Alemania despliega buque de guerra hacia el Mediterráneo por crisis en Ormuz
BERLÍN, (EFE).- El Gobierno de Alemania desplegó este lunes el buque "Fulda" hacia el mar Mediterráneo como medida preventiva ante el conflicto en Irán. El ministro de Defensa, Boris Pistorius, confirmó que el movimiento busca ganar tiempo estratégico en caso de que se concrete una misión internacional para liberar la navegación en el estrecho de Ormuz. No obstante, Berlín condicionó su participación a que se logre una tregua duradera y se cuente con un mandato parlamentario


Alemania despliega buque de guerra hacia el Mediterráneo por crisis en Ormuz
BERLÍN, (EFE).- El Gobierno de Alemania desplegó este lunes el buque "Fulda" hacia el mar Mediterráneo como medida preventiva ante el conflicto en Irán. El ministro de Defensa, Boris Pistorius, confirmó que el movimiento busca ganar tiempo estratégico en caso de que se concrete una misión internacional para liberar la navegación en el estrecho de Ormuz. No obstante, Berlín condicionó su participación a que se logre una tregua duradera y se cuente con un mandato parlamentario


Guerra en Irán asfixia al sector aéreo: Aerolíneas recortan rutas y dejan aviones en tierra
BANGKOK, (EFE).- El tráfico aéreo en la región de Asia-Pacífico registra una caída del 10% debido al impacto de la guerra en Irán y los bloqueos en el estrecho de Ormuz. El encarecimiento drástico del queroseno, que llegó a superar los 230 dólares por barril en marzo, ha obligado a las aerolíneas a tomar medidas drásticas, incluyendo el recorte de rutas menos rentables y el almacenamiento de aeronaves ante la falta de suministros inmediatos. Aerolíneas de renombre como Japan


Petróleo da un giro inesperado y baja de precio tras una mañana récord
Texas, (EFE).- El mercado energético internacional vive una jornada de extrema volatilidad este jueves. Tras alcanzar máximos no vistos desde 2022, el barril de petróleo Brent frenó su escalada y dio un giro a la baja hacia el cierre de la tarde. A pesar de haber rozado los 126 dólares durante la madrugada, el crudo de referencia en Europa se estabilizó cerca de los 114 dólares, cortando una racha de ocho sesiones consecutivas al alza. Esta fluctuación responde a la tensión g


América pierde a Cristian Borja por lesión en plena liguilla
CIUDAD DE MÉXICO.- Las alarmas se encendieron en el nido de Coapa tras confirmarse la lesión de rodilla del defensor colombiano Cristian Borja. El zaguero sufrió una afectación en el ligamento colateral medial de la pierna derecha durante el intenso empate 3-3 contra los Pumas, lo que lo dejará fuera de actividad en la fase definitiva del torneo Clausura 2026. La baja de Borja representa un golpe crítico para el esquema del técnico André Jardine, ya que el colombiano era una


América pierde a Cristian Borja por lesión en plena liguilla
CIUDAD DE MÉXICO.- Las alarmas se encendieron en el nido de Coapa tras confirmarse la lesión de rodilla del defensor colombiano Cristian Borja. El zaguero sufrió una afectación en el ligamento colateral medial de la pierna derecha durante el intenso empate 3-3 contra los Pumas, lo que lo dejará fuera de actividad en la fase definitiva del torneo Clausura 2026. La baja de Borja representa un golpe crítico para el esquema del técnico André Jardine, ya que el colombiano era una


Liguilla al rojo vivo: Tigres y Chivas abren unos cuartos de final de pronóstico reservado
MONTERREY, (EFE) .- El fútbol mexicano enciende las pasiones con el inicio de los cuartos de final del Clausura 2026. Este sábado, los Tigres UANL recibirán a las Chivas del Guadalajara en un duelo marcado por el contraste: mientras el "Rebaño" llega como favorito por su posición en la tabla, el equipo felino presume una racha invicta de cuatro partidos y el antecedente de una reciente goleada sobre los tapatíos. El panorama para el Guadalajara luce complicado, ya que el técn


Todo igualado: Cruz Azul rescata el empate ante Rayadas en el último suspiro
Las Rayadas de Monterrey y Cruz Azul dividieron honores con un empate 1-1 en el arranque de los cuartos de final del Clausura femenino. En un duelo de alta intensidad física, la costarricense Valeria del Campo pasó de heroína a protagonista del infortunio, marcando el primer tanto para las regias al minuto 17 tras un tiro de esquina, pero concediendo el penal que sentenciaría la igualdad definitiva. A pesar del dominio defensivo mostrado por las regias durante casi todo el en


¡De México para el mundo! El Dr. Simi conquista Colombia con consultas a 5 dólares
BOGOTÁ. — La icónica figura del Dr. Simi continúa su imparable expansión internacional, consolidándose ahora en el mercado sudamericano con una red de 60 droguerías abiertas en apenas año y medio. Esta apuesta de la cadena mexicana Farmacias Similares , perteneciente al Grupo por un País Mejor , busca replicar en territorio colombiano el modelo de éxito que ya domina en México y Chile, sumando recientemente una nueva sucursal en el estratégico barrio de Chapinero . La estra


La Inteligencia Artificial se convierte en el motor de éxito para los pequeños emprendedores
Madrid, (EFE).- En vísperas del Día Mundial del Emprendimiento, la Fundación Microfinanzas BBVA (FMBBVA) destacó que la Inteligencia Artificial (IA) se ha consolidado como una aliada estratégica para los pequeños negocios. Según la organización, el uso de herramientas digitales está permitiendo que emprendedores en España y América Latina Eleven su competitividad, permitiéndoles gestionar sus finanzas de manera más eficiente y segura a través de la economía digital . La fun


Más de 85.000 personas llenan la plaza de Cibeles en un festival de música cristiana
Madrid, (EFE).- La plaza de Cibeles se convirtió en el escenario de una masiva celebración el pasado sábado, donde más de 85.000 personas se reunieron para conmemorar la Fiesta de la Resurrección . Este evento, que llega a su cuarta edición, fue un espacio para celebrar la fe cristiana a través de un concierto que fusionó música, alegría y un ambiente festivo y familiar. La programación, variada y atractiva, incluyó artistas de renombre y grupos populares entre los jóvenes


Novedad turística en Chiapas: Lanzan experiencia de pernocta en las márgenes del Cañón del Sumidero
Chiapa de Corzo, Chiapas. – En las profundidades del emblemático Cañón del Sumidero , surge una propuesta que redefine el contacto con la naturaleza: el Campamento Paraíso . Este espacio, liderado por Rudy Pérez Pérez, se aleja de los recorridos turísticos tradicionales para ofrecer una estancia sustentable y auténtica en una de las zonas más impresionantes del estado. La experiencia comienza con el desafío físico. Para llegar a este refugio, los visitantes deben realizar un
bottom of page